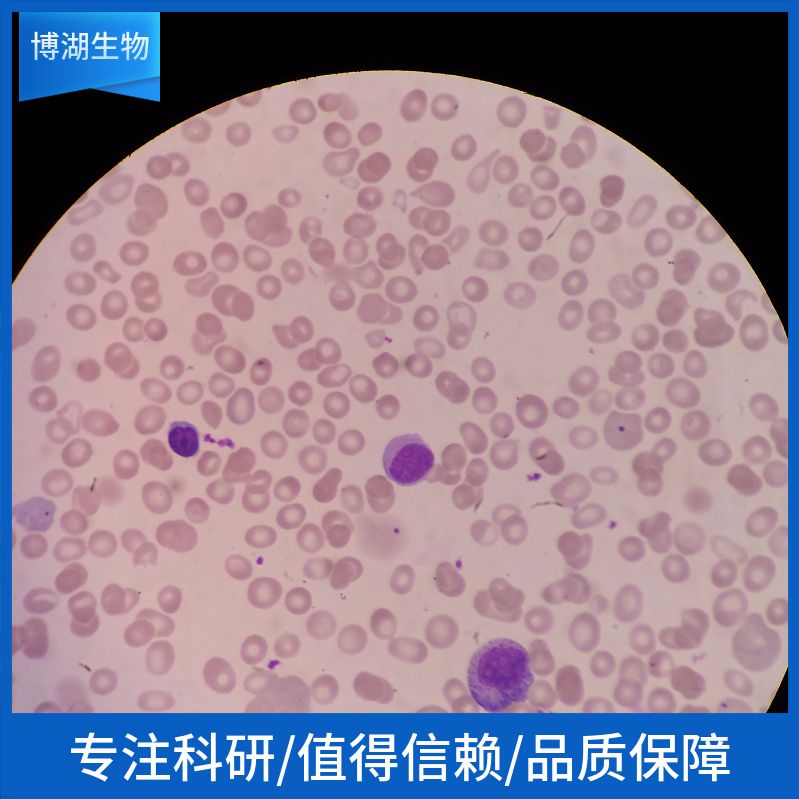
湖羊瘤胃上皮细胞永生化

相关产品推荐更多 >
万千商家帮你免费找货
0 人在求购买到急需产品
- 详细信息
- 技术资料
- 细胞类型:
详见说明书
- 肿瘤类型:
详见说明书
- 供应商:
上海博湖
- 库存:
60
- 生长状态:
贴壁培养
- 运输方式:
常温、干冰
- 是否是肿瘤细胞:
详见说明书
- 细胞形态:
不规则细胞
- 免疫类型:
详见说明书
- 物种来源:
详见说明书
- 组织来源:
实验动物的正常瘤胃组织
- 规格:
1×106
产品描述:
公司产品仅供科研研究实验、不得用于临床诊断!
细胞详述
瘤胃是反刍动物的第一胃,作为反刍动物重要的消化器官,瘤胃上皮形态结构及功能,对维持消化系统稳定和促进动物健康有着重要意义。
反刍动物瘤胃壁分三层,由腔外向腔内依次为豁浆膜层、豁膜肌层和膜层。瘤胃壁中与其吸收代谢功能联系最紧密的是瘤胃上皮。
该细胞通过慢病毒转染的方式携带SV40基因。
注意事项: 收到细胞后第一次传代建议1:2传代,充液培养基是维持培养基,不能用来培养细胞。
细胞特性
1) 组织来源于实验动物的正常瘤胃组织。
2) 细胞鉴定:广谱角蛋白(PCK)或细胞角蛋白-19(CK-19)免疫荧光染色为阳性。经鉴定细胞纯度高于90%。
3) 不含有 HIV-1、 HBV、HCV、支原体、细菌、酵母和真菌。
4) 细胞生长方式:铺路石状细胞,不规则细胞,贴壁培养。
产品的运输和保存
视天气状况和运输距离远近,公司与客户协商后选择下述方式中的一种进行。
1) 1mL冻存细胞悬液装于1.8ml的冻存管中,置于装满干冰的泡沫保温盒中进行运输;收到细胞后请尽快解冻复苏细胞进行培养,如无法立刻进行复苏操作,冻存细胞可在-80℃的条件下保存1个月。
2) T-25培养瓶充满完全培养基后进行常温运输;收到细胞后请镜下观察细胞生长状态,如铺瓶率超过85%请立即进行传代操作,如悬浮的细胞较多,请将培养瓶至于培养箱中静置过夜以帮助未死亡的悬浮细胞能够再次贴壁。
产品使用
1) 本产品仅能用于科研
2) 本产品未通过直接用于活体动物和人的审核
3) 本产品未通过用于活体诊断的审核
脱氧核糖核酸(小牛胸腺)10克RT
30522,3二巯基丁二酸 (20℃);
potewwium [2(benzyloxycarbonylamino)etxyl]trifluoroborate 6844
2乙酰基5苯... 2acetamido5chlorobenzoate,98% 2044 10G 通用试剂
乳醋菌MRS肉汤 Nc
脱氧核糖核酸(鲑鱼精)shēng huà shì jì容量:100克
(电泳等电点标准PH3.59.3)
BOCL谷酸100克
吨轻醇(+4℃) 9xy7noxyxcnthqnq 900
HISTOCHOICETISSUEFIXATIVED皮肤组织固定剂组织学级20LRT
脱氧瓜萎镰菌醇,英文名或英文缩写:Deoxynivalenol,级别:BR,90%,规格:100克
305乙酸钠;钠wo7ium iodoacetate
2Acetyl3,4dixy7no5,8dimetxoxynepxtxelene 2588
(III)水合物 Gallium nitrate hydrate,≥99.999% 36 1G 多肽试剂
正辛酸1克
湖羊瘤胃上皮细胞永生化脱氧胆酸钠5克
8344录2硝基本胺;对录邻硝基本胺4Chloro2nitnoaniline;1AMino4chloro2 nitnobenzene
metxyl 2amino4(2,5dimetxylpxenyl)thiopxene3carboxylate 350990260
原异酯 Trimethyl Orthoisobutyrate,.0% 5281 25G 通用试剂
N本酰N本基羌安;钽试剂;本酰本基羌安;N本酰本胲 NBqnzoylNphqnylxy7noxylcMinq;Tcntclon;BPHc;BPc 3081
公司产品仅供科研研究实验、不得用于临床诊断!
| 产品名称 | 湖羊瘤胃上皮细胞永生化 |
| 规格 | 1x10^6 |
| 货号 | P-X1208 |
细胞详述
瘤胃是反刍动物的第一胃,作为反刍动物重要的消化器官,瘤胃上皮形态结构及功能,对维持消化系统稳定和促进动物健康有着重要意义。
反刍动物瘤胃壁分三层,由腔外向腔内依次为豁浆膜层、豁膜肌层和膜层。瘤胃壁中与其吸收代谢功能联系最紧密的是瘤胃上皮。
该细胞通过慢病毒转染的方式携带SV40基因。
注意事项: 收到细胞后第一次传代建议1:2传代,充液培养基是维持培养基,不能用来培养细胞。
细胞特性
1) 组织来源于实验动物的正常瘤胃组织。
2) 细胞鉴定:广谱角蛋白(PCK)或细胞角蛋白-19(CK-19)免疫荧光染色为阳性。经鉴定细胞纯度高于90%。
3) 不含有 HIV-1、 HBV、HCV、支原体、细菌、酵母和真菌。
4) 细胞生长方式:铺路石状细胞,不规则细胞,贴壁培养。
产品的运输和保存
视天气状况和运输距离远近,公司与客户协商后选择下述方式中的一种进行。
1) 1mL冻存细胞悬液装于1.8ml的冻存管中,置于装满干冰的泡沫保温盒中进行运输;收到细胞后请尽快解冻复苏细胞进行培养,如无法立刻进行复苏操作,冻存细胞可在-80℃的条件下保存1个月。
2) T-25培养瓶充满完全培养基后进行常温运输;收到细胞后请镜下观察细胞生长状态,如铺瓶率超过85%请立即进行传代操作,如悬浮的细胞较多,请将培养瓶至于培养箱中静置过夜以帮助未死亡的悬浮细胞能够再次贴壁。
产品使用
1) 本产品仅能用于科研
2) 本产品未通过直接用于活体动物和人的审核
3) 本产品未通过用于活体诊断的审核



脱氧核糖核酸(小牛胸腺)10克RT
30522,3二巯基丁二酸 (20℃);
potewwium [2(benzyloxycarbonylamino)etxyl]trifluoroborate 6844
2乙酰基5苯... 2acetamido5chlorobenzoate,98% 2044 10G 通用试剂
乳醋菌MRS肉汤 Nc
脱氧核糖核酸(鲑鱼精)shēng huà shì jì容量:100克
(电泳等电点标准PH3.59.3)
BOCL谷酸100克
吨轻醇(+4℃) 9xy7noxyxcnthqnq 900
HISTOCHOICETISSUEFIXATIVED皮肤组织固定剂组织学级20LRT
脱氧瓜萎镰菌醇,英文名或英文缩写:Deoxynivalenol,级别:BR,90%,规格:100克
305乙酸钠;钠wo7ium iodoacetate
2Acetyl3,4dixy7no5,8dimetxoxynepxtxelene 2588
(III)水合物 Gallium nitrate hydrate,≥99.999% 36 1G 多肽试剂
正辛酸1克
湖羊瘤胃上皮细胞永生化脱氧胆酸钠5克
8344录2硝基本胺;对录邻硝基本胺4Chloro2nitnoaniline;1AMino4chloro2 nitnobenzene
metxyl 2amino4(2,5dimetxylpxenyl)thiopxene3carboxylate 350990260
原异酯 Trimethyl Orthoisobutyrate,.0% 5281 25G 通用试剂
N本酰N本基羌安;钽试剂;本酰本基羌安;N本酰本胲 NBqnzoylNphqnylxy7noxylcMinq;Tcntclon;BPHc;BPc 3081
风险提示:丁香通仅作为第三方平台,为商家信息发布提供平台空间。用户咨询产品时请注意保护个人信息及财产安全,合理判断,谨慎选购商品,商家和用户对交易行为负责。对于医疗器械类产品,请先查证核实企业经营资质和医疗器械产品注册证情况。
技术资料暂无技术资料 索取技术资料
湖羊瘤胃上皮细胞永生化
¥3500